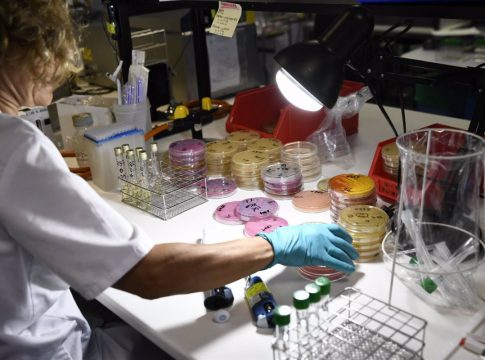
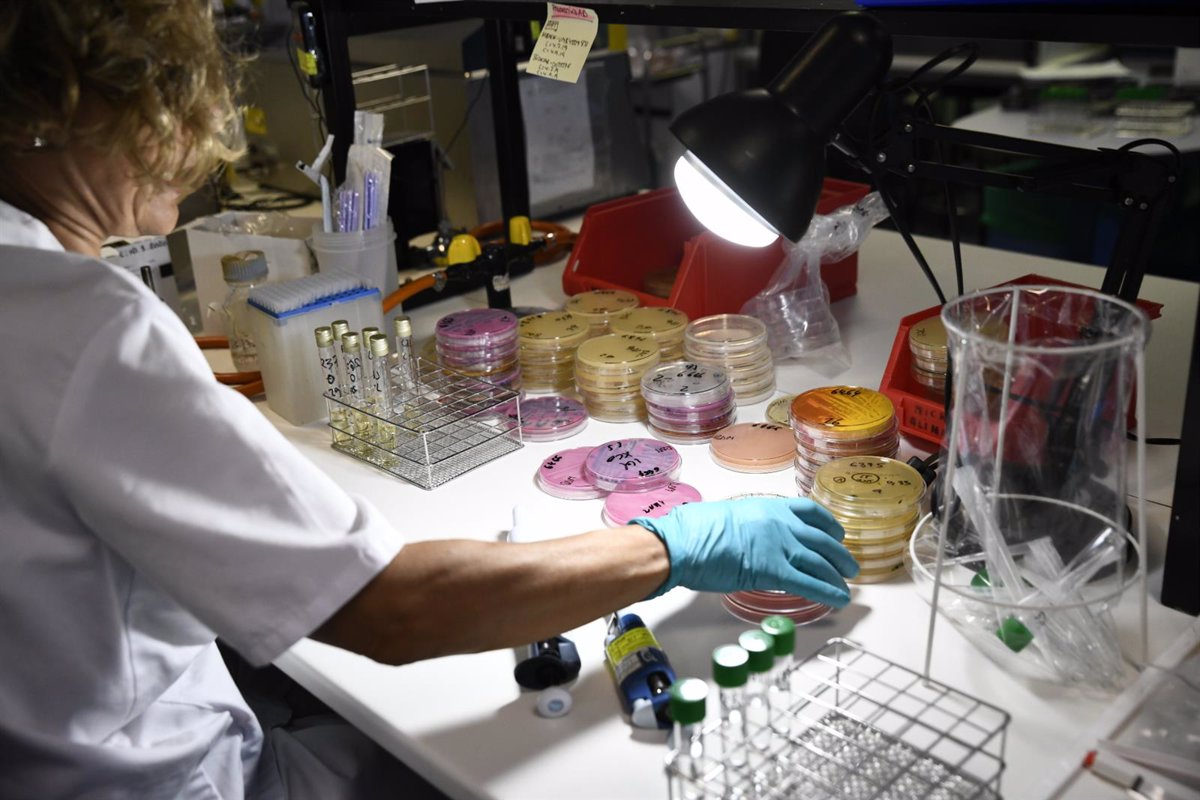

El Gobierno ha aprobado 699 nuevas plazas para científicos y técnicos de apoyo a la investigación en los Organismos Públicos de Investigación (OPI), lo que supone un aumento del 28% respecto a 2020, según informa el Ministerio de Ciencia e Innovación.
Esta Oferta de Empleo Público (OPE) permitirá la mayor captación de nuevo personal investigador y técnico en OPI desde 2007. Además, la oferta de empleo público contempla 364 plazas de promoción interna para estos organismos.
La ministra de Ciencia e Innovación, Diana Morant, ha destacado que esta oferta de empleo público pretende "fortalecer las plantillas" de los centros de investigación españoles. "Son puestos estables que nos permitirán rejuvenecer los equipos que buscan soluciones a los grandes retos de nuestra época: en cambio climático, en nuevos patógenos, en nuevos procesos de generación de energía verde, y también en investigación fundamental, en ciencias sociales o en matemáticas", ha señalado.
Tal y como explica el Ministerio, esta oferta para científicos y técnicos es posible gracias a que en 2021 son considerados sector prioritario, con una tasa de reposición del 110% frente a la 100% del resto de sectores.
La ministra ha recordado que la Ciencia y la Innovación son uno de los pilares en el Plan de Recuperación, Transformación y Resiliencia. Y esto también pasa por "cuidar y reforzar a las personas" que sustentan el sistema de I+D+I. Por eso, ha recordado, este año también se van a incrementar los contratos postdoctorales. "Atraer y retener talento es una de nuestras prioridades y el presupuesto para 2021, un 60% superior al anterior, nos permite impulsar este compromiso", ha indicado.
334 NUEVAS PLAZAS PARA LAS ESCALAS DE CIENTÍFICOS DE OPIS
Del total de nuevas plazas en esta oferta pública de empleo, 334 corresponden a las escalas de científicos de OPI (grupo A1), casi un 50% más que en 2020. Además, como novedad, por primera vez se convocarán plazas de tecnólogos (grupo A1), en desarrollo de la Ley de Ciencia, la Tecnología y la Innovación de 2011.
Las plazas se repartirán entre los distintos Organismos Públicos de Investigación: el Consejo Superior de Investigaciones Científicas (CSIC) y sus tres Centros Nacionales (IEO, INIA e IGME), el Instituto de Salud Carlos III (ISCIII), el Centro de Investigaciones Energéticas, Medioambientales y Tecnológicas (CIEMAT), el Instituto de Astrofísica de Canarias (IAC) y el Instituto Nacional de Técnica Aeroespacial (INTA).